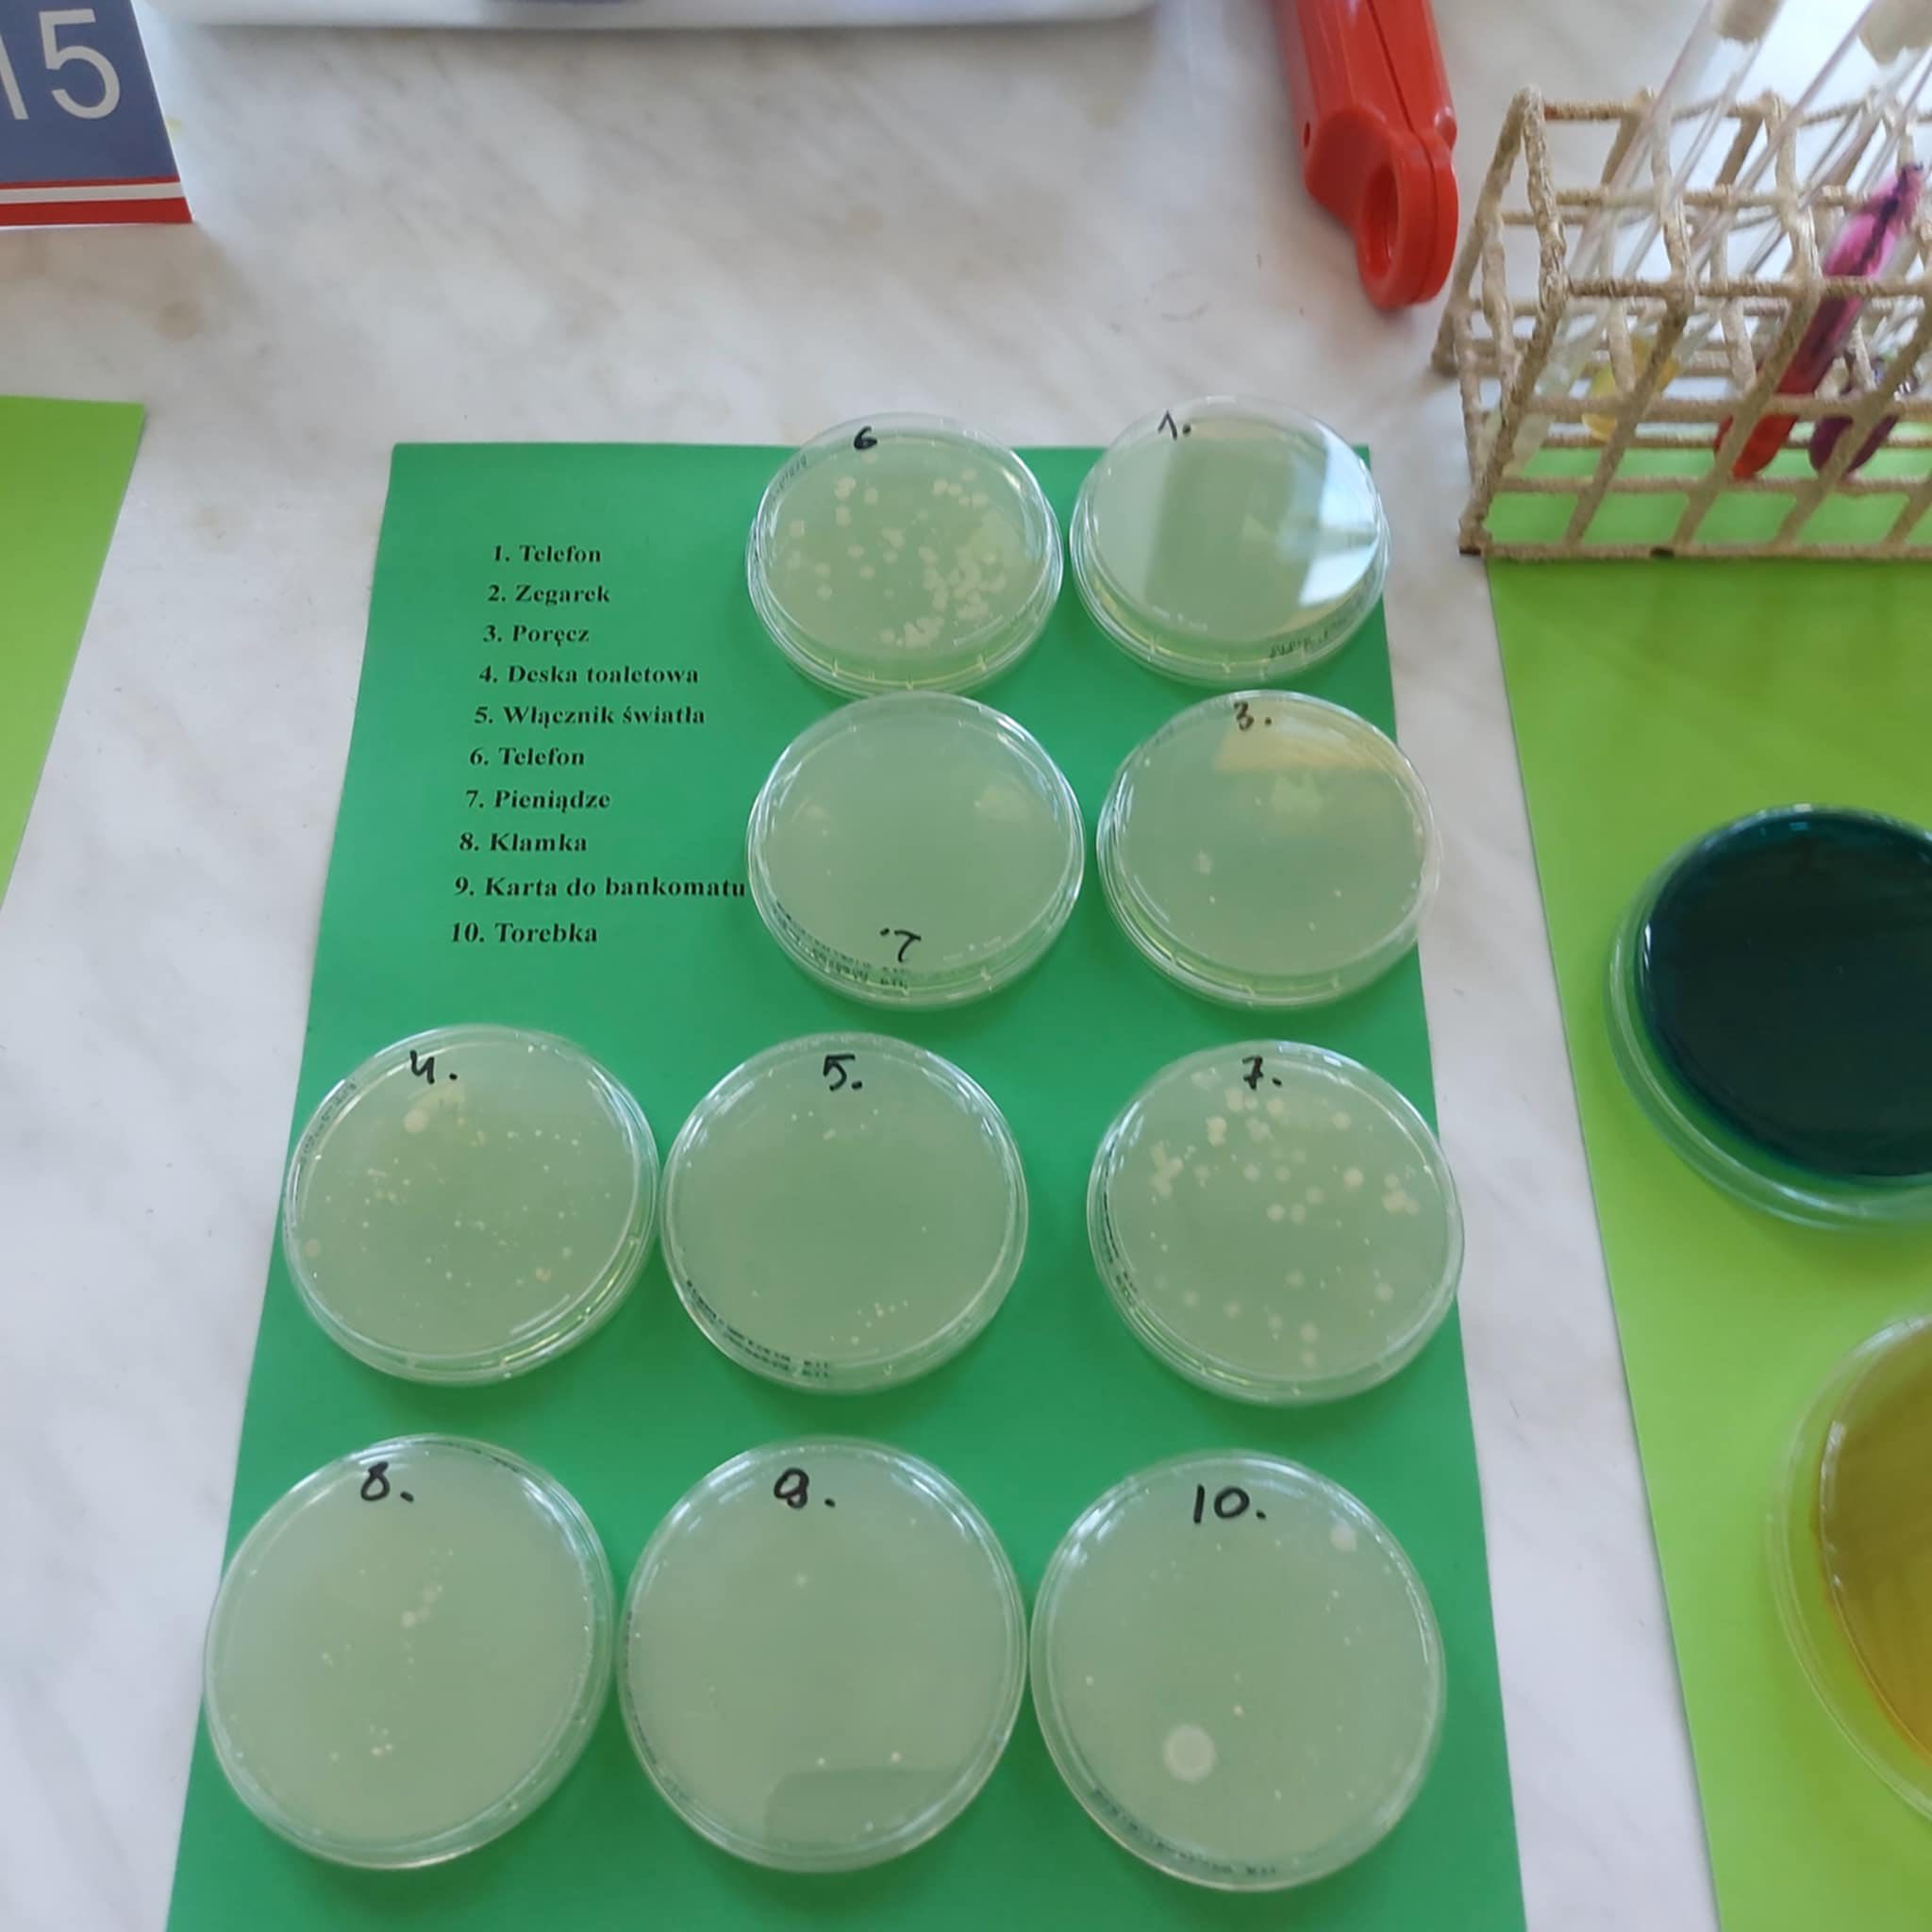

Uczniowie w Powiatowa Stacja Sanitarno-Epidemiologiczna w Białej Podlaskiej
Powiatowa Stacja Sanitarno-Epidemiologiczna w Białej Podlaskiej , z okazji Światowego Dnia Zdrowia zaprosiła do swojej siedziby uczniów bialskich szkół. Uczniowie klasy 2Tl z opiekunem Panią Grażyną Denicką oraz Bożeną Korniluk odwiedzili Laboratorium PSSE, gdzie mogli się dowiedzieć, na czym polega praca laboranta w tej instytucji. Zobaczyli m.in. pracownię bakteriologiczną, obejrzeli hodowle bakterii. Dla uczniów była to forma nietypowej lekcji, a dla pracowników PSSE prezentacją placówki, a także okazją do profilaktyki.
Wszystkim pracownikom PSSE w Białej Podlaskiej dziękujemy za zaproszenie oraz serdeczną atmosferę podczas naszej wizyty.
Poniżej fotorelacja:






Poniżej fotorelacja: